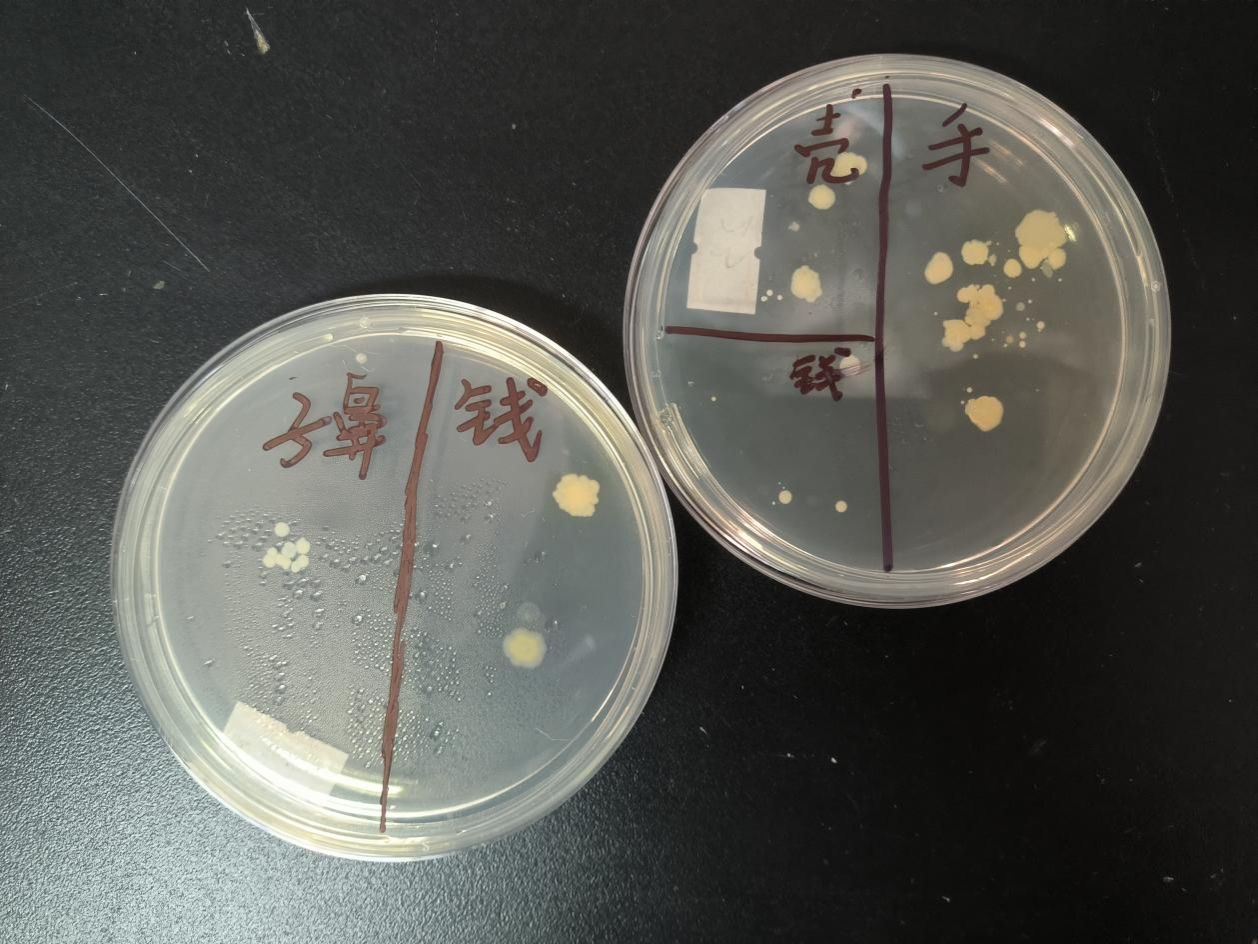

近年来,微生物引发的公共卫生事件频发,微生物在人体内外及环境中无处不在,直观的观察到身边物品甚至身体表面的微生物的培养形态及数量,有助于同学们加深对“微生物学”课程内容的理解。为提高海南医学院学生的观察现象、分析问题、思考对策和试验实操的能力,真正做到“知行合一”、“理论与实践相结合”的培养目标,热带医学院环境科学专业于2023年3月26日举办了“身边的微生物”课外实践活动!

同学们认真听讲
这次课外教学活动充分体现以学生为主体的学习理念,同学们自行分组,自行登记培养基编号、个人信息及培养物信息,以身边常见污染物为主要测试样本,从无菌操作,到不同物体表面的接种技巧,充分开动脑筋,发挥动手能力。这次比赛真正做到了考核指标“多位一体”、考核内容“丰富多样”、考核形式“立体全面”和考核宗旨“理论实践结合”。



实验操作一丝不苟
在活动过成中,同学们实际关注到无菌操作的各个环节,实验样本基本无污染。同时手脑并用,能在有限的无菌距离内借助工具完成各种形状物体表面的接种,提高了实验技能和解决实际问题的能力。现场实验结束后,我们对接种的微生物进行了培养。发现手机、眼睛、纸币上的细菌较多,袜子上真菌较多。我们将实验结果反馈给参加活动的同学,加强学生在生活中的卫生观念。

部分作品及全体教师、同学合影留念